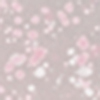
05 Pearl Drip - Gold & Pink Duo Chrome

01 Rose Swirl - Pearly Pink: Aqua (Water), C15-19 Alkane, Isoamyl Laurate, Mica, Glycerin, Propanediol, Squalane, Cetyl Peg/Ppg-10/1 Dimethicone, Polydecene, Hydrogenated Styrene/Isoprene Copolymer, Sodium Chloride, Disteardimonium Hectorite, Polyglyceryl-4 Isostearate, Hydroxyacetophenone, 1,2-Hexanediol, Caprylyl Glycol, Cetyl Dimethicone/Bis-Vinyldimethicone Crosspolymer, Triethoxycaprylylsilane, Trisodium Ethylenediamine Disuccinate, Methicone, Talc, Ascorbyl Tetraisopalmitate, Pentaerythrityl Tetra-Di-T-Butyl Hydroxyhydrocinnamate, Olea Europaea Fruit Water, Olea Europaea Fruit Extract (Olea Europaea (Olive) Fruit Extract), Potassium Sorbate, Sodium Benzoate, Lactic Acid, +/- May Contain: Ci 77891 (Titanium Dioxide), Ci 77491 (Iron Oxides), Ci 77492 (Iron Oxides), Ci 77499 (Iron Oxides)
02 Coral Splash - Golden Apricot: Aqua (Water), C15-19 Alkane, Isoamyl Laurate, Mica, Glycerin, Propanediol, Squalane, Cetyl Peg/Ppg-10/1 Dimethicone, Polydecene, Hydrogenated Styrene/Isoprene Copolymer, Sodium Chloride, Disteardimonium Hectorite, Polyglyceryl-4 Isostearate, Hydroxyacetophenone, 1,2-Hexanediol, Caprylyl Glycol, Cetyl Dimethicone/Bis-Vinyldimethicone Crosspolymer, Triethoxycaprylylsilane, Trisodium Ethylenediamine Disuccinate, Methicone, Talc, Ascorbyl Tetraisopalmitate, Pentaerythrityl Tetra-Di-T-Butyl Hydroxyhydrocinnamate, Olea Europaea Fruit Water, Olea Europaea Fruit Extract (Olea Europaea (Olive) Fruit Extract), Potassium Sorbate, Sodium Benzoate, Lactic Acid, +/- May Contain: Ci 77891 (Titanium Dioxide), Ci 77491 (Iron Oxides), Ci 77492 (Iron Oxides), Ci 77499 (Iron Oxides)
03 Red Sketch - Metallic Brick Red: Aqua (Water), C15-19 Alkane, Isoamyl Laurate, Mica, Glycerin, Propanediol, Squalane, Cetyl Peg/Ppg-10/1 Dimethicone, Polydecene, Hydrogenated Styrene/Isoprene Copolymer, Sodium Chloride, Disteardimonium Hectorite, Polyglyceryl-4 Isostearate, Hydroxyacetophenone, 1,2-Hexanediol, Caprylyl Glycol, Cetyl Dimethicone/Bis-Vinyldimethicone Crosspolymer, Triethoxycaprylylsilane, Trisodium Ethylenediamine Disuccinate, Methicone, Talc, Ascorbyl Tetraisopalmitate, Pentaerythrityl Tetra-Di-T-Butyl Hydroxyhydrocinnamate, Olea Europaea Fruit Water, Olea Europaea Fruit Extract (Olea Europaea (Olive) Fruit Extract), Potassium Sorbate, Sodium Benzoate, Lactic Acid, +/- May Contain: Ci 77891 (Titanium Dioxide), Ci 77491 (Iron Oxides), Ci 77492 (Iron Oxides), Ci 77499 (Iron Oxides)
04 Mauve Graffiti - Pearly Berry: Aqua (Water), C15-19 Alkane, Isoamyl Laurate, Mica, Glycerin, Propanediol, Squalane, Cetyl Peg/Ppg-10/1 Dimethicone, Polydecene, Hydrogenated Styrene/Isoprene Copolymer, Sodium Chloride, Disteardimonium Hectorite, Polyglyceryl-4 Isostearate, Hydroxyacetophenone, 1,2-Hexanediol, Caprylyl Glycol, Cetyl Dimethicone/Bis-Vinyldimethicone Crosspolymer, Triethoxycaprylylsilane, Trisodium Ethylenediamine Disuccinate, Methicone, Talc, Ascorbyl Tetraisopalmitate, Pentaerythrityl Tetra-Di-T-Butyl Hydroxyhydrocinnamate, Olea Europaea Fruit Water, Olea Europaea Fruit Extract (Olea Europaea (Olive) Fruit Extract), Potassium Sorbate, Sodium Benzoate, Lactic Acid, +/- May Contain: Ci 77891 (Titanium Dioxide), Ci 77491 (Iron Oxides), Ci 77492 (Iron Oxides), Ci 77499 (Iron Oxides)
05 Pearl Drip - Gold & Pink Duo Chrome: Aqua (Water), Silica, Acrylates Copolymer, Butylene Glycol, Ethylhexylglycerin, Sodium Hydroxide, Hydroxyacetophenone, 1,2-Hexanediol, Caprylyl Glycol, Pentylene Glycol, Hydroxyethylcellulose, Synthetic Fluorphlogopite, Ascorbyl Tetraisopalmitate, Sclerocarya Birrea Seed Oil, Sodium Hyaluronate, Squalane, Glycerin, Olea Europaea Fruit Water, Tin Oxide, Disodium Phosphate, Polysorbate 60, Tocopherol, Olea Europaea Fruit Extract (Olea Europaea (Olive) Fruit Extract), Sodium Phosphate, Potassium Sorbate, Sodium Benzoate, Lactic Acid, +/- May Contain: Ci 77891 (Titanium Dioxide), Ci 77491 (Iron Oxides)
06 Crystal Glaze - Transparent Wet Gloss: Hydrogenated Didecene, Hydrogenated Polydecene, Isododecane, Isoamyl Laurate, Hydrogenated Styrene/Isoprene Copolymer, Polyglyceryl-2 Isostearate/Dimer Dilinoleate Copolymer, 1,2-Hexanediol, Caprylyl Glycol, Ethyl Vanillin, Tocopherol, Solanum Lycopersicum Seed Oil (Solanum Lycopersicum (Tomato) Seed Oil), Pentaerythrityl Tetra-Di-T-Butyl Hydroxyhydrocinnamate
The list of ingredients is regularly updated. Please always read the list of ingredients on the packaging to ensure they are suitable for your personal use.